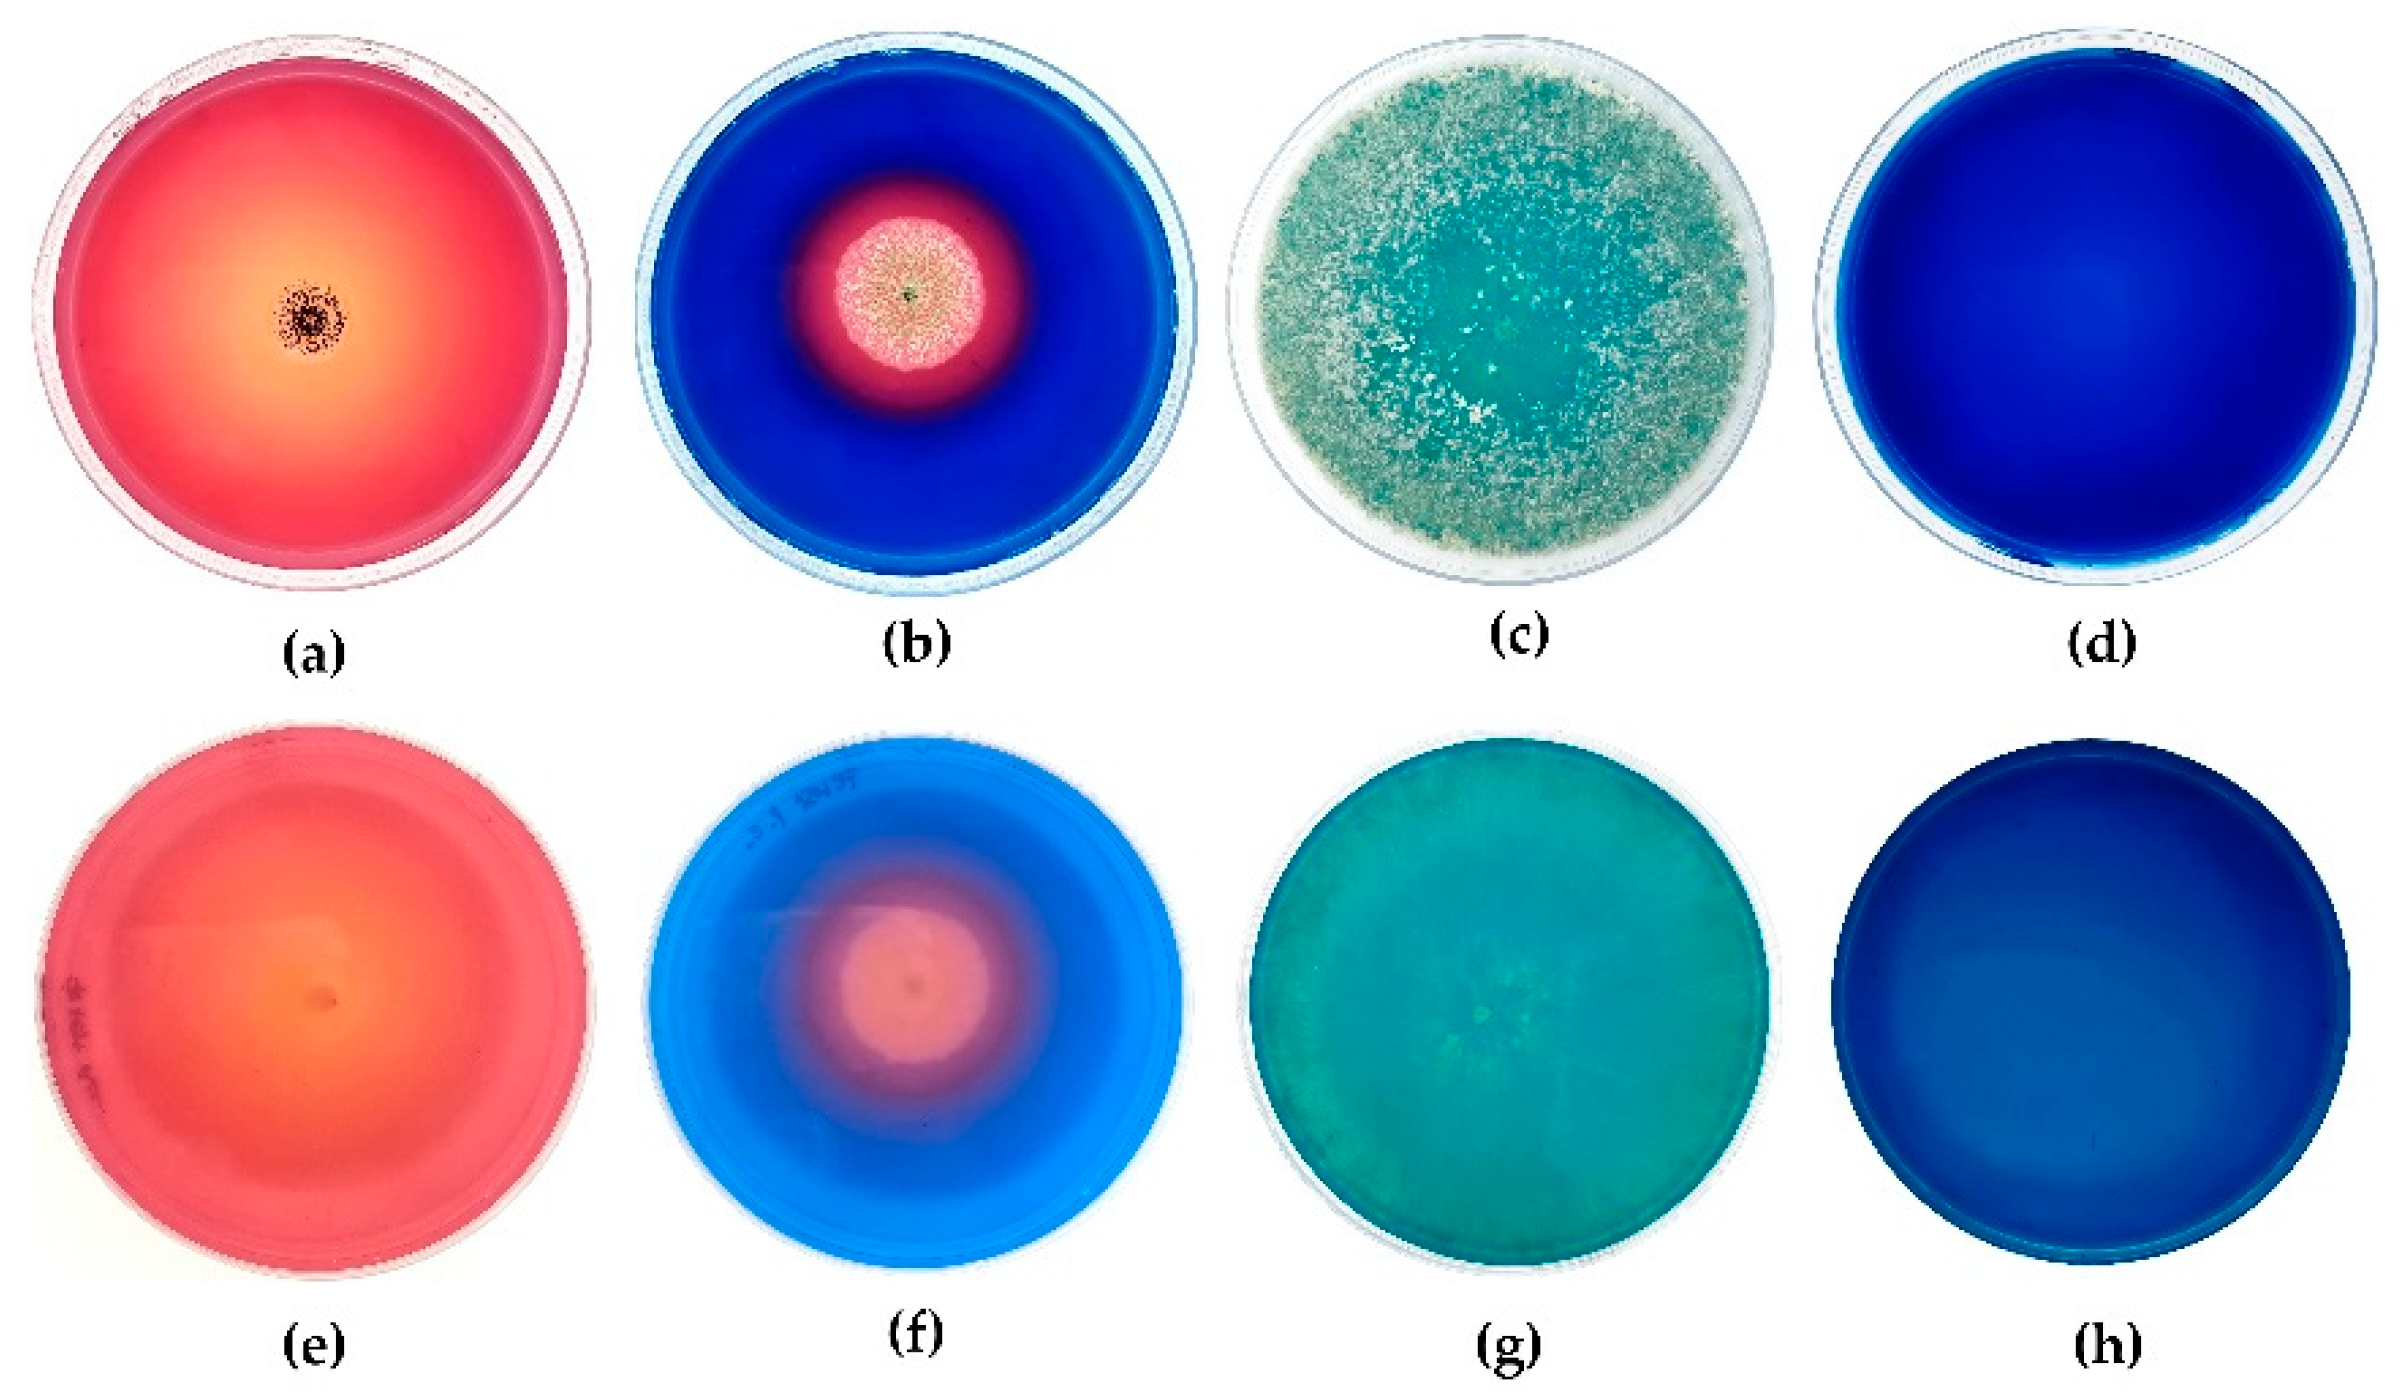
Recycling 07 00072 g001 Recycling 07 00072 g001

Applied Tests to Select the Most Suitable Fungal Strain for the Recovery of Critical Raw Materials from Electronic Waste Powder
Abstract
1. Introduction
2. Materials and Methods
2.1. E-Waste Processing and Analysis
2.2. Fungal Strains and Screening Test
2.3. Fungal Growth Dish Tests
2.4. Tolerance Index
2.5. Bioconcentration Factor (BCF)
3. Results
3.1. E-Waste Analysis
3.2. Fungal Strains and Screening Test
3.3. Fungal Growth Dish Tests
3.4. Tolerance Index
3.5. Bioconcentration Factor (BCF)
4. Discussions
5. Practical Implication of This Study
6. Conclusions
Author Contributions
Funding
Data Availability Statement
Conflicts of Interest
References
- Forti, V.; Balde, C.P.; Kuehr, R.; Bel, G. The Global E-Waste Monitor 2020: Quantities, Flows and the Circular Economy Potential; United Nations University/United Nations Institute for Training and Research: Bonn, Germany; International Telecommunication Union: Geneva, Switzerland; International Solid Waste Association: Rotterdam, The Netherlands, 2020; pp. 13–15.
- Yadav, A.N.; Singh, S.; Mishra, S.; Gupta, A. Recent Advancement in White Biotechnology through Fungi; Springer: Berlin/Heidelberg, Germany, 2019. [Google Scholar]
- Charter, L. Leipzig Charter on Sustainable European Cities. In Proceedings of the European Conference of Ministers Responsible for Spatial/Regional Planning, Resolution, Romania, 3 November 2007; Volume 3. [Google Scholar]
- Dev, S.; Sachan, A.; Dehghani, F.; Ghosh, T.; Briggs, B.R.; Aggarwal, S. Mechanisms of Biological Recovery of Rare-Earth Elements from Industrial and Electronic Wastes: A Review. Chem. Eng. J. 2020, 397, 124596. [Google Scholar] [CrossRef]
- Yu, Z.; Han, H.; Feng, P.; Zhao, S.; Zhou, T.; Kakade, A.; Kulshrestha, S.; Majeed, S.; Li, X. Recent Advances in the Recovery of Metals from Waste through Biological Processes. Bioresour. Technol. 2020, 297, 122416. [Google Scholar] [CrossRef] [PubMed]
- Zotti, M.; Di Piazza, S.; Roccotiello, E.; Lucchetti, G.; Mariotti, M.G.; Marescotti, P. Microfungi in Highly Copper-Contaminated Soils from an Abandoned Fe-Cu Sulphide Mine: Growth Responses, Tolerance and Bioaccumulation. Chemosphere 2014, 117, 471–476. [Google Scholar] [CrossRef] [PubMed]
- Gu, T.; Rastegar, S.O.; Mousavi, S.M.; Li, M.; Zhou, M. Advances in Bioleaching for Recovery of Metals and Bioremediation of Fuel Ash and Sewage Sludge. Bioresour. Technol. 2018, 261, 428–440. [Google Scholar] [CrossRef] [PubMed]
- Di Piazza, S.; Cecchi, G.; Cardinale, A.M.; Carbone, C.; Mariotti, M.G.; Giovine, M.; Zotti, M. Penicillium Expansum Link Strain for a Biometallurgical Method to Recover REEs from WEEE. Waste Manag. 2017, 60, 596–600. [Google Scholar] [CrossRef] [PubMed]
- Louden, B.C.; Haarmann, D.; Lynne, A.M. Use of Blue Agar CAS Assay for Siderophore Detection. J. Microbiol. Biol. Educ. 2011, 12, 51–53. [Google Scholar] [CrossRef] [PubMed]
- Rasband, W.S. ImageJ; National Institutes of Health: Bethesda, MD, USA, 1997.
- Ghosh, S.K.; Banerjee, S.; Sengupta, C. Siderophore Production by Antagonistic Fungi (Coleoptera: Chrysomelidae: Bruchinae) © 527 Bioassay, Characterization and Estimation of Siderophores from Some Important Antagonistic Fungi. J. Biopest. 2017, 10, 105–112. [Google Scholar]
- Cecchi, G.; Roccotiello, E.; Di Piazza, S.; Riggi, A.; Mariotti, M.G.; Zotti, M. Assessment of Ni Accumulation Capability by Fungi for a Possible Approach to Remove Metals from Soils and Waters. J. Environ. Sci. Health Part B 2017, 52, 166–170. [Google Scholar] [CrossRef] [PubMed]
- Jakubiak, M.; Giska, I.; Asztemborska, M.; Bystrzejewska-Piotrowska, G. Bioaccumulation and Biosorption of Inorganic Nanoparticles: Factors Affecting the Efficiency of Nanoparticle Mycoextraction by Liquid-Grown Mycelia of Pleurotus Eryngii and Trametes Versicolor. Mycol. Prog. 2014, 13, 525–532. [Google Scholar] [CrossRef]
- Gadd, G.M. Geomycology: Biogeochemical Transformations of Rocks, Minerals, Metals and Radionuclides by Fungi, Bioweathering and Bioremediation. Mycol. Res. 2007, 111, 3–49. [Google Scholar] [CrossRef] [PubMed]
- Schwyn, B.; Neilands, J.B. Universal Chemical Assay for the Detection and Determination of Siderophores. Anal. Biochem. 1987, 160, 47–56. [Google Scholar] [CrossRef]
- Cecchi, G.; Ceci, A.; Marescotti, P.; Persiani, A.M.; Di Piazza, S.; Zotti, M. Interactions among Microfungi and Pyrite-Chalcopyrite Mineralizations: Tolerance, Mineral Bioleaching, and Metal Bioaccumulation. Mycol. Prog. 2019, 18, 415–423. [Google Scholar] [CrossRef]
- Osman, Y.; Gebreil, A.; Mowafy, A.M.; Anan, T.I.; Hamed, S.M. Characterization of Aspergillus Niger Siderophore That Mediates Bioleaching of Rare Earth Elements from Phosphorites. World J. Microbiol. Biotechnol. 2019, 35, 93. [Google Scholar] [CrossRef] [PubMed]
- Bhattacharya, S.; John, P.J.; Ledwani, L. Microbial Siderophores an Envisaged Tool for Asbestos Bioremediation—A Microcosm Approach. Mater. Today Proc. 2021, 43, 3110–3116. [Google Scholar] [CrossRef]
- Zhao, J.; Liu, W.; Liu, D.; Lu, C.; Zhang, D.; Wu, H.; Dong, D.; Meng, L. Identification and Evaluation of Aspergillus Tubingensis as a Potential Biocontrol Agent against Grey Mould on Tomato. J. Gen. Plant Pathol. 2018, 84, 148–159. [Google Scholar] [CrossRef]
- Machuca, A.; Milagres, A.M.F. Use of CAS-Agar Plate Modified to Study the Effect of Different Variables on the Siderophore Production by Aspergillus. Lett. Appl. Microbiol. 2003, 36, 177–181. [Google Scholar] [CrossRef] [PubMed]
- Abo-Elyousr, K.A.M.; Marei Almasaudi, N. Application of Trichoderma Harzianum Strain KABOFT4 for Management of Tomato Bacterial Wilt Under Greenhouse Conditions. Gesunde Pflanz. 2022, 74, 413–421. [Google Scholar] [CrossRef]
- Becci, A.; Karaj, D.; Merli, G.; Beolchini, F. Biotechnology for Metal Recovery from End-of-Life Printed Circuit Boards with Aspergillus niger. Sustainability 2020, 12, 6482. [Google Scholar] [CrossRef]
- Wang, W.; Xu, C.; Jin, Y.; Zhang, Z.; Yan, R.; Zhu, D. The Accumulation of Rare-Earth Yttrium Ions by Penicillium sp. ZD28. AMB Express 2020, 10, 1–11. [Google Scholar] [CrossRef] [PubMed]
- Jakubek, L.M.; Marangoudakis, S.; Raingo, J.; Liu, X.; Lipscombe, D.; Hurt, R.H. The Inhibition of Neuronal Calcium Ion Channels by Trace Levels of Yttrium Released from Carbon Nanotubes. Biomaterials 2009, 30, 6351–6357. [Google Scholar] [CrossRef] [PubMed]

| Element | La | Nd | Tb | Y | Al | Fe | Sn | Cu | Ag | Pd | Pt | Au |
|---|---|---|---|---|---|---|---|---|---|---|---|---|
| Concentration (ppm) | 0.26 | 1.27 | 1.1 | 1.7 | 6213 | 7833 | 3165 | 487 | 868 | 93 | 50 | 628 |
| Fungal Strain | Halo Presence | Diameter of Halo (cm) | Diameter of Colony (cm) | Ratio |
|---|---|---|---|---|
| Aspergillus tubingensis | +++ | 9 | 1.43 | 6.29 |
| Penicillium glandicola | ++ | 4.13 | 2.51 | 1.65 |
| Trichoderma harzianum | + | n.d. | 9 | n.d. |
| Strain | Specific Weight for 1 mm2 of Mycelium |
|---|---|
| Aspergillus tubingensis | 0.620 mg |
| Penicillium glandicola | 0.397 mg |
| Trichoderma harzianum | 0.269 mg |
| Strain | pH (Day 1) | pH (Day 18) |
|---|---|---|
| Aspergillus tubingensis | 5.6 | 1 |
| Penicillium glandicola | 5.6 | 4 |
| Trichoderma harzianum | 5.6 | 8 |
| Strain | Tolerance Index (TI) |
|---|---|
| Aspergillus tubingensis | 1.03 ± 0.11 |
| Penicillium glandicola | 0.64 ± 0.13 |
| Trichoderma harzianum | 1 ± 0 |
Publisher’s Note: MDPI stays neutral with regard to jurisdictional claims in published maps and institutional affiliations. |
© 2022 by the authors. Licensee MDPI, Basel, Switzerland. This article is an open access article distributed under the terms and conditions of the Creative Commons Attribution (CC BY) license (https://creativecommons.org/licenses/by/4.0/).
Share and Cite
Rosa, E.; Di Piazza, S.; Cecchi, G.; Mazzoccoli, M.; Zerbini, M.; Cardinale, A.M.; Zotti, M. Applied Tests to Select the Most Suitable Fungal Strain for the Recovery of Critical Raw Materials from Electronic Waste Powder. Recycling 2022, 7, 72. https://doi.org/10.3390/recycling7050072
Rosa E, Di Piazza S, Cecchi G, Mazzoccoli M, Zerbini M, Cardinale AM, Zotti M. Applied Tests to Select the Most Suitable Fungal Strain for the Recovery of Critical Raw Materials from Electronic Waste Powder. Recycling. 2022; 7(5):72. https://doi.org/10.3390/recycling7050072
Chicago/Turabian StyleRosa, Ester, Simone Di Piazza, Grazia Cecchi, Michela Mazzoccoli, Micol Zerbini, Anna Maria Cardinale, and Mirca Zotti. 2022. "Applied Tests to Select the Most Suitable Fungal Strain for the Recovery of Critical Raw Materials from Electronic Waste Powder" Recycling 7, no. 5: 72. https://doi.org/10.3390/recycling7050072
APA StyleRosa, E., Di Piazza, S., Cecchi, G., Mazzoccoli, M., Zerbini, M., Cardinale, A. M., & Zotti, M. (2022). Applied Tests to Select the Most Suitable Fungal Strain for the Recovery of Critical Raw Materials from Electronic Waste Powder. Recycling, 7(5), 72. https://doi.org/10.3390/recycling7050072

